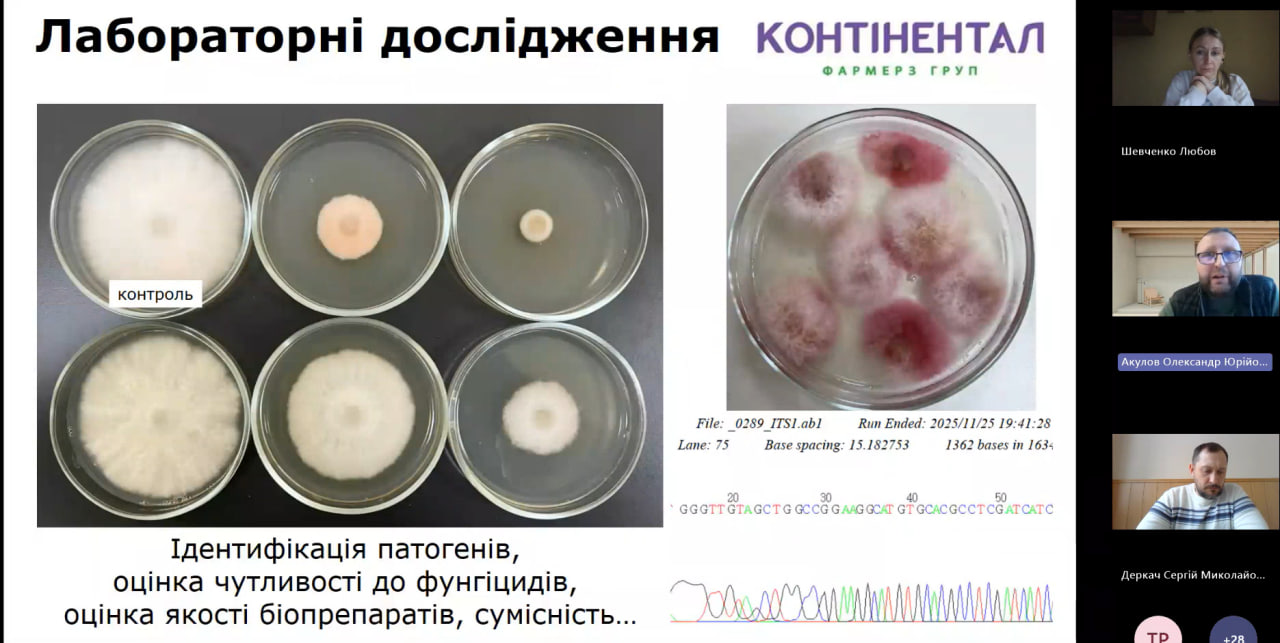

Гостьова лекція для ЗВО спеціальності “Агрономія” «Методологія польових досліджень ефективності ЗЗР: стаціонарний і виробничий формати»
5 лютого 2026 р. відбулася гостьова лекція для ЗВО спеціальності “Агрономія” на тему: «Методологія польових досліджень ефективності ЗЗР: стаціонарний і виробничий формати»
Доповідач: Акулов Олександр Юрійович, кандидат біологічних наук, начальник науково-дослідного відділу Контінентал Фармерз Груп, доцент кафедри фізіології та біохімії рослин і мікроорганізмів Харківського національного університету імені В.Н. Каразіна, Заслужений працівник освіти України
У ході лекції було детально розглянуто теоретичні та практичні аспекти закладання й методику проведення польових досліджень, спрямованих на оцінку ефективності застосування засобів захисту рослин (ЗЗР) у різних умовах. Особливу увагу приділено проведенню досліджень у межах стаціонарних і виробничих форматів, їх ролі в науковому обґрунтуванні технологій захисту сільськогосподарських культур.
Розкрито логіку та послідовність проведення агрономічних досліджень, починаючи з лабораторного етапу, де вивчаються фізико-хімічні та біологічні властивості препаратів, далі — вегетаційного, який дозволяє оцінити вплив ЗЗР на ріст і розвиток рослин у контрольованих умовах. Наступними етапами є стаціонарні польові досліди, що забезпечують отримання багаторічних даних за стабільних умов, а також виробничі досліди, метою яких є перевірка ефективності препаратів у реальних умовах господарства.
Окремо було розглянуто принципи формування варіантів досліду, включаючи підбір контролю, кількість повторень, площу облікових ділянок і дотримання вимог випадковості та репрезентативності. Значну увагу приділено методам збору експериментальних даних, зокрема обліку чисельності шкідливих організмів, ступеня ураження рослин хворобами, фітотоксичності препаратів, а також показників урожайності та якості продукції.
У завершальній частині лекції було продемонстровано сучасні методи обробки та аналізу отриманих результатів, зокрема використання статистичних методів, електронних таблиць і спеціалізованого програмного забезпечення, що дозволяє підвищити точність інтерпретації даних і обґрунтованість наукових висновків.